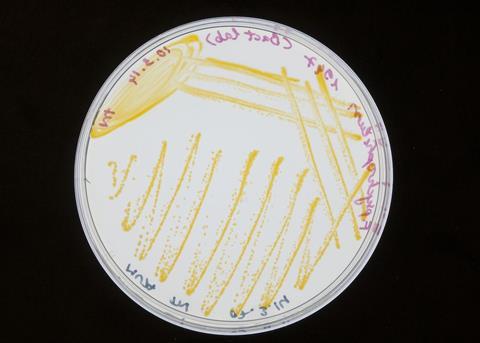
?High Hopes for New Rainbow Trout Vaccine

Significant steps are being taken in Scotland to develop a commercial vaccine for rainbow trout fry syndrome (RTFS).
RTFS is a systemic bacterial disease with a worldwide distribution, resulting in substantial economic losses in the rainbow trout industry, including the UK. Caused by the bacterium Flavobacterium psychrophilum, RTFS is widespread and occurs frequently at water temperatures between 10-14°C. It affects rainbow trout ranging in size from 0.2g - 100g, leaving necrotic lesions on the skin surrounding the dorsal fin and tail. In very small fish no clinical signs are apparent and death occurs due to septicaemia. RTFS can lead to high mortalities in fry and larger fish in freshwater hatcheries and on-growing sites. An average early stage mortality of 10% in rainbow trout could be considered normal in many production sites.
Although disease outbreaks have been recorded in Europe since the late 80s, the lack of knowledge regarding the epidemiology of Flavobacterium psychrophilum has limited the development of disease management tools. Antibiotics are currently the only course of action to contain disease outbreaks. In the UK, RTFS is an important issue as rainbow trout are the second most produced finfish by harvest volume.
Now, a new RTFS vaccine is due to be tested during field trials to improve fish welfare in the rainbow trout industry and secure the necessary license for commercial use. Dawnfresh, one of the UK’s largest rainbow trout producers, and the University of Stirling’s Institute of Aquaculture (IoA), are leading the initiative, while Scottish trout farmer Kames Fish Farming and aquaculture research firm Tethys Aquaculture will also be working on the project with funding from the Scottish Aquaculture Innovation Centre (SAIC). The vaccine was developed as part of a five-year European project called ‘TARGETFISH’ that aimed to prevent important fish diseases in European aquaculture through a targeted vaccination strategy.
“The lack of an effective vaccine to prevent RTFS has hampered the expansion of the trout industry in Scotland and the UK for decades,” said Professor Sandra Adams at the University of Stirling. “Such a vaccine is urgently required but progress has been slow due to the diversity of bacterial isolates on different farms and the fact that small fish (fry) need to be vaccinated, i.e. they are too small to be injected. However, through TARGETFISH, we have developed an effective immersion for small fish and our work is now proceeding to field trials in a new SAIC funded project.”
Lab testing and field trials
The new vaccine is a dip vaccine, which can be administered to trout fry in a low stress and low risk manner. Rainbow trout fry will be dipped in the vaccine for 30 seconds and important data on vaccine efficacy will be gathered during the field trials. This information is required because repeat laboratory testing of the immersion vaccine has not been possible due to difficulties in performing a standardised experimental immersion challenge in vaccinated fish. The field trials are due to be performed on fish farms that have significant annual challenges from RTFS. They will be set up and monitored by the University of Stirling in conjunction with veterinarians on the farms.
“Vaccines are recognised as important tools for the prevention and control of fish diseases and are used routinely in aquaculture,” Professor Adams said. “They prevent disease so if they are successful, they will reduce the need for treatment with antibiotics. Another benefit of the new vaccine is that although it’s been developed for use in the UK, the isolates included in the vaccine could be modified for use in other trout aquaculture regions of the world.”
Fish vaccines have been difficult to develop. In a paper published earlier this year in the journal Fish and Shellfish Immunology, Adams explains that determining optimal vaccine administration methods is one of the challenges being faced. Although some vaccines being developed offer protection, it’s possible that vaccination strategies and current administration methods aren’t appropriate for optimal efficacy. The diversity of fish species can also be an issue, she says, as different fish immune systems are not yet fully understood, and new reagents/primers are required to elucidate host pathogen interactions.
Developing effective vaccines
However, Sandra Adams says that the most crucial step in developing an effective vaccine is being able to identify ‘potentially’ protective antigens and confirming their protective response in the host species against the pathogen of interest. The approach taken depends on pathogen type, fish species, administration method, availability of reagents, and whether a challenge model has been developed to test the vaccine candidates.
“It’s not easy to identify protective antigens,” she explained. “It requires a variety of approaches, and the majority of commercial vaccines are killed whole cell pathogen preparations administered by intraperitoneal injection. This may not be the optimal route to deliver some vaccines, but a lack of effective adjuvants and basic knowledge on immune response has hindered progress in the development of mucosal vaccines. The cost of injecting fish may also be prohibitive in some countries.”
Despite this, however, vaccination is an important disease management strategy. In aquaculture vaccines are used routinely, especially in species such as Atlantic salmon but in a more limited capacity or not at all in other fish species due to a lack of vaccines, poor performance or cost issues. Vaccination has been recognised as essential to reducing antibiotics use within the aquaculture industry in the UK and Norway, although overuse or inappropriate use has been reported in various fish species in other regions of the world.
Professor Adams says that when attempting to reduce antibiotics usage in aquaculture, it is important to continue developing fish vaccines for use in all aquaculture fish species where possible. The use of immunostimulants and probiotics should also be encouraged.
New approaches are becoming increasingly necessary in aquaculture’s drive to minimise the use of antibiotics, reduce losses and improve fish welfare. The University of Stirling is playing a major role in this field by working towards a sustainable foundation for trout farming in the UK. In a press release, high hopes were expressed that the RTFS vaccine, together with best farm management practices, will offer protection to fry, the stage most susceptible to infection from F. psychrophilum.